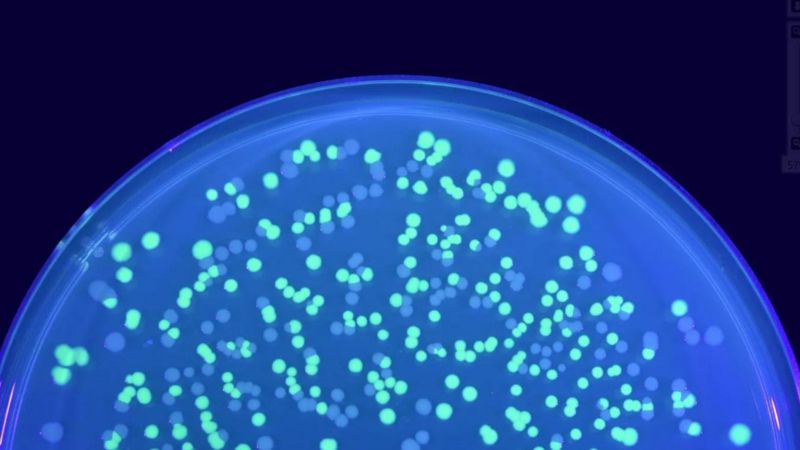

فرانس کے نیشنل انسٹیٹیوٹ آف ہیلتھ اینڈ میڈیکل ریسرچ میں انسانی جینوم کی سینیئر سائنسدان ڈینا زائلنسکی جب پیرس میں اپنے گھر سے ہم سے ویڈیو کال پر بات کر رہی تھیں تو اُنھوں نے ایک چھوٹی سی شیشی ہمیں کیمرے کے سامنے کر کے دکھائی۔
اس شیشی کے اندر کی چیز کو پہچاننا مشکل تھا مگر اُنھوں نے کہا کہ میں اس چیز کو غور سے دیکھوں تو مجھے شیشی کی تہہ میں ایک صاف اور باریک سی فلم نظر آئے گی جو ’ڈی این اے‘ ہے۔
مگر یہ ڈی این اے خاص ہے۔ یہ کسی انسانی جینوم کا کوڈ نہیں ہے اور نہ ہی کسی جانور یا وائرس کا کوڈ ہے۔ اس کے بجائے یہ ایک میوزیم کا ڈیجیٹل نمونہ ہے۔
ڈینا کہتی ہیں کہ ’یہ آسانی سے شاید سینکڑوں سال تک باقی رہے گا۔
گذشتہ ایک دہائی میں انسانی جینوم کی ترتیب سمجھنے (سیکوئنسنگ)، ڈی این اے کی تیاری اور جینیاتی طریقہ علاج کی کھوج کے ساتھ ساتھ ڈی این اے کے اندر ڈیٹا سٹور کرنے کے حوالے سے بھی خاصی تحقیق ہوئی ہے۔
سائنسدانوں نے ڈی این اے کے اندر فلمیں، کتابیں اور یہاں تک کہ کمپیوٹر آپریٹنگ سسٹمز تک انکوڈ کر رکھے ہیں۔ نیٹ فلکس نے تو اسے اپنی سنہ 2020 کی تھرلر سیریز ’بائیو ہیکرز‘ کی ایک قسط سٹور کرنے کے لیے بھی استعمال کیا ہے۔
ڈی این اے میں محفوظ معلومات ہی انسان کو انسان بناتی ہیں اور ایسا دیگر انواع میں بھی ہوتا ہے۔ مگر کئی ماہرین کا کہنا ہے کہ یہ ڈیٹا سٹور کرنے کا ایک انتہائی چھوٹا، پائیدار اور طویل مدتی طریقہ ہے جو ہمیں فی الوقت دستیاب کئی ناقابلِ بھروسہ ڈیجیٹل سٹوریج میڈیمز کی جگہ لے سکتا ہے کیونکہ یہ باقاعدگی سے خراب ہو سکتے ہیں اور انھیں سٹور کرنے کے لیے کافی توانائی چاہیے ہوتی ہے۔
اسی دوران کئی ماہرین اس بات پر تحقیق کر رہے ہیں کہ کیا ہم مؤثر انداز میں ہمیشہ کے لیے ڈیٹا کو محفوظ بنا سکتے ہیں؟ اس کا ایک طریقہ انتہائی مضبوط شیشے کے دانوں پر ڈیٹا کو کندہ کرنا ہے جو غاروں میں موجود نقاشی کی ایک جدید شکل ہو گی۔
مگر یہ ڈیٹا واقعتاً کتنے عرصے تک باقی رہ سکتا ہے اور کیا ہم واقعی اس میں اتنی بڑی تعداد میں ڈیٹا محفوظ کر سکتے ہیں؟
ایسے وقت میں جب ہماری دنیا پہلے سے زیادہ ڈیجیٹلائز ہوتی جا رہی ہے، ڈیٹا پر ہمارا انحصار بڑھتا جا رہا ہے۔ فلمیں، تصاویر، ویب سائٹس، کاروباری دستاویزات، اہم سکیورٹی ریکارڈز، غرض یہ کہ ہمارے زیرِ استعمال ہر چیز ڈیجیٹلائزڈ ہے اور ہم پہلے سے زیادہ اس پر انحصار کر رہے ہیں۔
ہمارا پیدا کردہ زیادہ تر ڈیٹا 0 اور 1 کی شکل میں ہارڈ ڈرائیوز جیسی مقناطیسی ٹیپس میں محفوظ ہے مگر یہ کوئی اتنا مثالی طریقہ نہیں۔ سب سے پہلی بات تو یہ کہ ڈی میگنیٹائزیشن یعنی اپنی مقناطیسی قوت کھو دینا ایک بہت بڑا مسئلہ ہے۔
مقناطیس وقت کے ساتھ ساتھ اپنی قوت کھو دیتے ہیں اس لیے ڈیٹا کو محفوظ رکھنے کے لیے ہر چند برسوں بعد ہارڈ ڈرائیوز دوبارہ ری رائیٹ کرنا اہم ہے۔ زائلنسکی کہتی ہیں کہ ’یہ اوسطاً 10 سے 20 برسوں تک چل سکتا ہے اور اگر آپ کی قسمت اچھی ہو اور حالات سازگار ہوں تو 50 برس تک بھی باقی رہ سکتا ہے۔‘

ڈیٹا سٹور کرنے کے لیے بہت بڑے ڈیٹا سینٹرز کی بھی ضرورت ہوتی ہے جنھیں خود کو ٹھنڈا رکھنے کے لیے بے تحاشہ توانائی کی ضرورت ہوتی ہے اور یہ توانائی کے بحران کی شکار دنیا کے لیے کوئی اچھی بات نہیں۔ اس مسئلے کو دنیا بھر میں نہایت سنگین تصور کیا جاتا ہے، یہاں تک کہ امریکی حکومت کا سنہ 2019 میں لانچ کیا گیا مالیکیولر انفارمیشن سٹوریج پروگرام بھی آج کے بڑے ڈیٹا سٹوریج مراکز کے لیے توانائی کے متبادل ذرائع ڈھونڈنے میں کوشاں ہے۔
ڈینا کہتی ہیں کہ ’اصل میں ہمارے پاس ہارڈویئر ہی ختم ہو رہا ہے۔ مجھے لگتا ہے کہ انڈسٹری اتنی جلدی اتنی بڑی تعداد میں ہارڈ ڈسکس اور سرورز نہیں بنا پا رہی کہ اس ڈیٹا کو سٹور کیا جائے۔‘
مگر کی ہمیں واقعی یہ سارا ڈیٹا رکھنے اور اسے اتنے طویل عرصے تک محفوظ رکھنے کی ضرورت ہے؟
لوگ کئی وجوہات کی بنا پر طویل مدت کے لیے ڈیٹا سٹور کرنا چاہتے ہیں۔ ایک تو سائنس ہے۔ محققین اب پہلے سے کہیں زیادہ بڑی تعداد میں ڈیٹا پیدا کر رہے ہیں اور ان کے پاس جتنا زیادہ ڈیٹا ہو اتنا اچھا ہے۔
مثال کے طور پر، لاس الاموس نیشنل لیبارٹری میں ڈی این اے سٹوریج پر کام کرنے والے کمپیوٹر سائنسدان لاچیزار لنکوو کہتے ہیں میں ریڈیو دوربینیں اور پارٹیکل ایکسلریٹر جیسے لارج ہیڈرون کولائیڈر (LHC)، ڈیٹا کی بڑی بڑی مقدار تیار کرتے ہیں، اور سائنس دان چاہتے ہیں کہ یہ تمام چیزیں محفوظ رہیں۔ صرف لارج ہیڈرون کولائیڈر میں ہر سال 90 پیٹا بائٹس (90 ملین گیگا بائٹس) ڈیٹا تیار ہوتا ہے۔
میساچوسٹس انسٹیٹیوٹ آف ٹیکنالوجی (ایم آئی ٹی) میں حیاتیاتی انجینئرنگ کے پروفیسر مارک باتھ نے بائیو مالیکیولز کو وسیع پیمانے پر قابل رسائی اور کارآمد بنانے کے لیے سٹارٹ اپ کیشے ڈی این اے کی مشترکہ بنیاد رکھی۔ باتھ کا کہنا ہے کہ انسانیت کو درپیش عالمی خطرات ہمیں انسانی ساختہ معلومات، جیسے آرٹ اور سائنس، اور کرہ ارض پر موجود تمام جانداروں کے ڈی این اے دونوں کو محفوظ رکھنے پر مجبور کرتے ہیں۔
وہ کہتے ہیں کہ ’اس طرح اگر زندگی کو یا تو یہاں دوبارہ بنایا جائے یا دوسری صورت میں دوسرے سیاروں سے منتقل یا درآمد کیا جائے اور اسی طرح ہم نے کیا کیا، اور ہمارے پاس کیا تھا اس کا ریکارڈ موجود ہو گا۔‘
بہت سے ڈی این اے سٹوریج کرنے والے محققین کا خیال ہے کہ انھوں نے وسیع اور ناقابل یقین حد تک طویل مدتی سٹوریج دونوں کے لیے بہترین سٹوریج میڈیم تیار کرنے کا تہیہ کیا ہوا ہے۔ ہم عام طور پر ڈی این اے کو جینومک معلومات کو ذخیرہ کرنے کے ایک طریقہ کے طور پر دیکھتے ہیں، لیکن بہت سے محققین اب ڈیجیٹل ڈیٹا کی وسیع مقدار کو ذخیرہ کرنے کے امکان کے بارے میں پرجوش ہیں جو اس وقت پوری دنیا کے ڈیٹا سینٹرز کی گنجایش سے زیادہ ہوتے جا رہے ہیں۔
باتھ کہتے ہیں کہ یہاں ڈی این اے ایک قدرتی انتخاب ہے۔ وہ کہتے ہیں کہ ’قدرت نے کئی ہزار سالوں سے ڈی این اے کو جینوم کی شکل میں معلومات کو ذخیرہ کرنے کے لیے استعمال کیا ہے۔ یہ تقریباً (اربوں سالوں سے) محفوظ ہے، یہ ایک ایسی چیز ہے جس پر آپ ایک طرح سے انحصار کر سکتے ہیں۔ جب تک کہ یہ انسانوں کی طرح کسی نوع کی بنیادی معلومات کو ذخیرہ کرنے کا ذریعہ ہے، تب تک یہ کچھ ایسا ہو گا جس کے ساتھ ہمیں کیا کرنا ہے۔‘

زیلنسکی کا کہنا ہے کہ اس حقیقت کا موازنہ کریں کہ گذشتہ 3.7 ارب سالوں میں ڈی این اے کو انفارمیشن ایج سے بہتر بنایا گیا ہے، جو واقعی 1950 کی دہائی میں شروع ہوا تھا۔
’ہم انسانی ساختہ ٹیکنالوجی میں بہت آگے آ چکے ہیں، لیکن کارکردگی کے لحاظ سے یہ ڈی این اے سے زیادہ بہتر نہیں ہے – جب ہم ایک سیل کے طور پر شروع کرتے ہیں تو ان کے لیے تمام ہدایات موجود ہوتی ہیں کہ ہر ایک سیل کو اس وقت تک ہدایت دیں جب تک کہ آپ تقریباً ایک ایک خلیے تک نہ پہنچ جائیں۔ ینعی 30 کھرب خلیات جو ایک انسان کی تشکیل کرتے ہیں۔’
زیلنسکی کا کہنا ہے کہ اس کے ساتھ ساتھ حقیقت یہ ہے کہ ہم لاکھوں سال پرانے جانوروں سے ڈی این اے کے ٹکڑوں کو بازیافت کر سکتے ہیں جیسے کہ اونی میمتھ جو ان کے جینوم کے بارے میں بامعنی ڈیٹا فراہم کرتے ہیں یہ ظاہر کرتا ہے کہ ڈی این اے ناقابل یقین حد تک پائیدار ہے۔ ڈی این اے کی نصف زندگی – جو وقت اسے نصف سے کم ہونے میں لگتا ہے۔ ایک اچھی طرح سے محفوظ شدہ فوسل میں تقریبا 500 سال ہے، جس کا مطلب ہے کہ ڈی این اے تقریبا پندرہ لاکھ سالوں کے بعد پڑھے جانے کے قابل نہیں رہے گا۔
تاہم ڈی این اے ناقابل یقین حد تک نازک ہے، اور وہ حالات جو فوسلائزیشن کا باعث بنتے ہیں غیر معمولی طور پر نایاب ہیں۔ یونیورسٹی آف الینوائے میں الیکٹریکل اور کمپیوٹر انجینئرنگ کی پروفیسر اربانا-شیمپین سے وابستہ اولگیکا میلینکووچ کہتی ہیں کہ ‘اس کو تباہ کرنے کے بہت سارے طریقے ہیں۔’ نمی، تیزاب اور تابکاری سبھی ڈی این اے کو نقصان پہنچاتے ہیں۔ ‘لیکن اگر اسے ٹھنڈا اور خشک رکھا جائے تو یہ سینکڑوں سالوں کے لیے برقرار رہ سکتے ہیں۔
س سے بھی بہتر، ڈی این اے کو دوسرے مواد جیسے شیشے کے موتیوں کے اندر سمیٹ کر محفوظ کیا جا سکتا ہے، یہ نقل کرتے ہوئے کہ قدیم فوسلز میں جینیاتی مواد کیسے محفوظ ہے۔ ای ٹی ایچ زیورخ، سوئٹزرلینڈ کے ایک محقق، رابرٹ گراس اور ان کی ٹیم نے دکھایا ہے کہ یہ موتیوں کو کیمیکلز اور گرمی دونوں سے ڈی این اے کی حفاظت کرتے ہیں۔
اسے جسمانی طور پر محفوظ جگہ پر تلاش کرنے سے مزید تحفظ حاصل ہو سکتا ہے۔ میلینکووچ کہتے ہیں کہ انسانیت کے لیے انتہائی اہم ڈیٹا کو برف کی تہہ میں بند ڈی این اے میں ذخیرہ کرنے کا مطلب یہ ہو سکتا ہے کہ ’یہ ہمیشہ کے لیے قائم رہ سکتا ہے، بہت زیادہ عرصے کے لیے۔‘
ڈی این اے کا ایک اور بڑا فائدہ یہ ہے کہ یہ معلومات کا ناقابل یقین حد تک بہت بڑا ذخیرہ ہے جس کی مثال انسان کے بنائے کسی بھی دوسرے آلے سے نہیں دی جا سکتی ہے۔ لنکوو کے مطابق، تخمینہ شدہ 33 زیٹا بائٹس ڈیٹا جو انسان 2025 تک تیار کر چکے ہوں گے (یہ ایسا ایک ہندسہ ہے جس میں 3.3 کے بعد 22 مرتبہ زیرو لکھے جائیں گے) کو ڈی این اے اسٹوریج کے ساتھ پنگ پونگ گیند کے سائز میں ٹحفوظ کیا جا سکتا ہے۔
ان کا خیال ہے کہ ڈی این اے میں اتنی زیادہ معلومات کو ذخیرہ کرنا اب محض چند دہائیاں دور کی بات ہو سکتی ہے۔دوسرے انسان ساختہ سٹوریج میڈیا کے برعکس ڈی این اے سٹوریج کے کبھی بھی متروک ہونے کا امکان نہیں ہے۔
میلینکووچ پوچھتے ہیں کہ ’ہم میں سے اب بھی کون ہیں جو فلاپی ڈسک استعمال کرتا ہے؟‘ ڈی این اے کے ساتھ، ہمیں ہمیشہ اسے پڑھنے کے قابل ہونا چاہیے۔ زیلنسکی کا کہنا ہے کہ ’ہر انسانی ساختہ ٹیکنالوجی کے ساتھ آپ کو اسے پڑھنے کے لیے ایک نئے آلے کی ضرورت ہوتی ہے۔ اگر ڈی این اے متروک ہو جاتا ہے، تو پھر ہمیں فکر کرنے کے لیے دیگر مسائل ہیں۔‘

’اِمورٹیلیٹی پروجیکٹ‘
یہ مضمون اِمورٹیلیٹی پراجیکٹ کا حصہ ہے۔ ہم اس بات کی کھوج لگا رہے ہیں کہ ایک ایسی وراثت حاصل کرنے کے لیے کیا ضرورت ہے جو صرف دہائیوں تک نہیں بلکہ ہزاروں سال تک قائم رہتی ہے۔ طویل المدت سینڈوچ سے لے کر قابل عزت علم، آرٹ اور یہاں تک کہ مذاہب تک، ہم یہ جاننا چاہتے ہیں کہ کچھ چیزیں ہزاروں یا لاکھوں سال تک کیسے زندہ رہتی ہیں، اور اس بصیرت کا استعمال یہ دیکھنے کے لیے کریں کہ آیا دنیا پر کوئی نشان چھوڑنا ممکن ہے یا نہیں۔ جو کہ گہرے مستقبل تک پھیلا ہوا ہے۔ مضامین، ویڈیوز اور تجربات ہوں گے۔ ہم میں سے کوئی اپنے پیر کے ناخنوں کے تراشوں کو جیواشم (فوسالائیزنگ) کی صورت دے سکتا ہے یا نہیں۔۔۔
میلینکووچ نوٹ کرتے ہیں کہ ڈی این اے سٹوریج کے دیگر فوائد بھی ہیں۔ اس نے پہلے ہی طبی سائنس میں تحقیق، جیسا کہ جین تھراپی اور مصنوعی حیاتیات سے استفادہ کیا ہے اور یہ تحقیق آگے بڑھتے ہی جاری رہے گی۔ یہ ذخیرہ کرنے کے آلات بغیر توانائی کے استعمال بھی کام کریں گے۔
یقیناً یہ بہت بڑے چیلنجز ہیں۔ جیسا کہ 2018 کے ایک مقالے میں کہا گیا ہے، جبکہ ڈی این اے میں ’مستقبل کے ڈیٹا سٹوریج ڈیوائس کے طور پر ایک بہت بڑی صلاحیت ہے، متعدد رکاوٹیں جیسے کہ بہت زیادہ لاگت، لکھنے اور پڑھنے کے انتہائی سست طریقہ کار، اور تغیرات یا غلطیوں کے خطرے کو حل کرنے کی ضرورت ہے۔‘
ڈیجیٹل ڈیٹا کو ڈی این اے میں تبدیل کرنے کا عمل بنیادی طور پر اسے ڈی این اے کے الفابیٹ (حروفِ تہجی) میں تبدیل کرنے پر مشتمل ہوتا ہے۔ ڈی این اے چار مالیکیولز سے بنا ہے جنھیں نیوکلیوٹائڈز یا بیس کہا جاتا ہے: ایڈنائن (A)، سائٹوسین (C)، گوانائن (G)، اور تھامین (T)، جو ایک لمبی تار میں مختلف ترتیبوں میں آپس میں جڑے ہوئے ہیں
ڈیجیٹل معلومات کو ڈی این اے کوڈ میں تبدیل کرنے کا سب سے عام طریقہ صرف ڈیجیٹل کوڈ کے صفروں(0) اور ایک (1) کے ہندسوں میں تبدیل کرنے کی ضرورت ہے، پھرڈی این اے کو میچ کرنے کے لیے سنتھیسز (ترکیب) دینا ہے۔
میلینکووچ کہتے ہیں کہ ’مثال کے طور پر، آپ 00؛ T 01 کی نمائندگی کے لیے A کا استعمال کر سکتے ہیں؛ G 10 اور C، 11 کی نمائندگی کے لیے استعمال کر سکتے ہیں۔ پھر آپ کوئی بھی ڈیجیٹل مواد لے سکتے ہیں جو کلاسیکی طور پر ڈسک یا ٹیپ یا فلیش پر موجود ہو، اور اسے چار حرفی حروف تہجی میں تبدیل کر سکتے ہیں۔‘
ڈی این اے سِنتھیسز وہ طریقہ تھا جو 2012 اور 2013 میں شائع ہونے والے دو تاریخ ساز تحقیقی مقالے کے ذریعہ استعمال کیا گیا تھا جس میں سے ہر ایک نے ڈی این اے میں تقریباً 700کلو بائیٹس ڈیٹا محفوظ کیا تھا (پچھلا ریکارڈ 1 کلو بائیٹ سے کم تھا)۔
2017 کے ایک تحقیقی مقالے میں، زیلنکسی (اس وقت نیو یارک جینوم سینٹر کی ایک محقق) اور اس کے ساتھیوں نے اس طریقہ کار کو استعمال کرتے ہوئے ڈی این اے پر ایک سائنسی تحقیقی مقالہ، ایک منٹ کی فلم، کمپیوٹر آپریٹنگ سسٹم، کمپیوٹر وائرس اور ایمیزون گفٹ کارڈ – کل تقریباً 2 میگا بائیٹس سٹور کیا۔
ڈی این اے پر بہت سارے ڈیٹا کو ذخیرہ کرنے میں بڑی رکاوٹ یقیناً لاگت ہے، جو کہ کمپیٹر سرورز یا ہارڈ ڈسک پر ڈیٹا سٹور کرنے سے کہیں زیادہ ہے۔ ان پانچ ڈیجیٹل اشیا کو ذخیرہ کرنے کے لیے زیلنکسی کو ساڑھے سات ہزار ڈالر خرچ کرنے پڑے تھے۔
زیلنسکی کہتی ہیں ڈی این اے سٹوریج کی لاگت ایک حرکت کرتے ہوئے ہدف کی مانند ہے کیونکہ یہ سِنتھیسز کے طریقہ کار کے ساتھ ساتھ انکوڈنگ اسکیم اور اسے ڈی کوڈ کرنے کے طریقہ پر منحصر ہوتا ہے۔ وہ کہتی ہیں کہ ایک معقول تخمینہ لگ بھگ چند ہزار ڈالر فی میگا بائٹ (ایم بی) ہے جو سنتھیسز کے ذریعے انکوڈ اور ڈی کوڈ دونوں کے لیے ہوتا ہے۔
مثال کے طور پر اس آرٹیکل اور اس کی تصویروں کو ڈی این اے میں تبدیل کرنے کا مطلب یہ ہو گا کہ ابتدائی طور پر ڈیٹا کو تقریباً 20 میگا بائیٹس سے 500 کلو بائٹس تک کمپریس کرنا، ایک انکوڈنگ سکیم کو لاگو کرنا، پھر اسے 1,000 ڈالر کی معمولی لاگت پر سنتھیسائز کرنے کے لیے لیب میں بھیجنا۔
زیلنسکی کا کہنا ہے کہ ’یہ لیب میرے لیے ایک ایسی تکنیک کا استعمال کرتے ہوئے اسے بنانے کے محنت کش عمل کو مکمل کرے گی جو ڈی این اے کے ہر تار میں ایک وقت میں ایک نیوکلیوٹائڈ کا اضافہ کرتی ہے۔ سب سے بڑی رکاوٹ دراصل اس ڈی این اے کا سِنتھیسز کرنا ہے۔ یہ سب سے بڑی توجہ ہے، ترکیب کے اخراجات کو کم کرنا۔‘
تاہم اس کے نتیجے میں آنے والے تاروں کو کامل ہونے کی ضرورت نہیں ہے۔ اگر آپ اسے طبی طریقہ کار کے بجائے ڈیٹا اسٹوریج کے لیے استعمال کر رہے ہیں – جس کے لیے ڈی این اے کی سِنتھاسیز اصل میں تیار کی گئی تھی – تو غلطیوں کے لیے لچکدار اور انھیں برداشت کرنے کی صلاحیت رکھتی ہے۔
لہذا سِنتھاسیز کے تیز، کم درست طریقوں کے لیے دروازہ کھلا ہے۔ زیلنسکی کا کہنا ہے کہ ’آپ ڈیٹا میں ہونے والی غلطیوں کو سنبھال سکتے ہیں اور پھر بھی اپنی فائلوں کو بازیاب کر سکتے ہیں۔ اور اس طرح ہم بہت زیادہ گڑبڑ کو بھی سنبھال سکتے ہیں۔‘
باتھ کا کہنا ہے کہ عام ڈیجیٹل میڈیا کے ساتھ مقابلہ کرنے کے لیے، ڈی این اے سٹوریج کی لاگت میں تقریباً ایک ملین کے فیکٹر سے کم ہونا پڑے گا۔ یہ بہت دور کے مستقبل کی بات ہے، لیکن سائنسدان پہلے ہی اس بات کو بڑھانے کے لیے کام کر رہے ہیں کہ ایک ہی وقت میں کتنے ڈی این اے مالیکیول لکھے جا سکتے ہیں۔
باتھ کہتے ہیں کہ ’اگر آپ الیکٹرانکس کی صنعت کو دیکھیں تو انھوں نے لاگت میں کمی دیکھی ہے۔‘ وہ مزید کہتے ہیں کہ اور ڈی این اے کی ترکیب کی قیمت پہلے ہی نمایاں طور پر گر چکی ہے۔
ایک اور آپشن جو مکمل طور پر ترکیب سے گریز کرتا ہے قدرتی طور پر پائے جانے والے ڈی این اے میں ڈیٹا کو ذخیرہ کرنے کا امکان ہے جس میں صرف ترمیم کی گئی ہے۔
2020 میں، میلینکووچ کے گروپ نے امریکی صدر ابراہم لنکن کے گیٹس برگ ایڈریس اور لنکن میموریل کی تصویر کو ذخیرہ کرنے کے لیے بیکٹیریا ای کولی سے ڈی این اے میں ترمیم کی تاکہ سوراخ بنانے کے لیے ایک پنچ کارڈ سسٹم بنایا جا سکے (دراصل جین ایڈیٹنگ سسٹم کا استعمال کرتے ہوئے نیوکلیوٹائڈز سے باہر نکلنے والے چھوٹے نکات۔ جیسے کرسپر اور دیگر نکنگ انزائمز) بیکٹیریا کی جینیاتی سِنتھاسیز میں۔ یہ مکمل طور پر نئے ڈی این اے مالیکیول بنانے سے کہیں زیادہ سستا ہو سکتا ہے۔
’یہ بالکل مختلف نمونہ ہے۔ میلنکووچ کہتے ہیں کہ آپ اے ٹی جی سی ) کی ساخت میں ترتیب کے مواد میں معلومات کو ذخیرہ نہیں کرتے ہیں، آپ معلومات کو ڈبل ہیلکس میں ساختی تبدیلیوں کی موجودگی میں ذخیرہ کرتے ہیں۔‘
وہ کہتی ہیں کہ اصل بیکٹیریا کوڈ کے لیے حوالہ نقطہ بن جاتا ہے، اور کسی سِنتھاسیز کی ضرورت نہیں ہے، جس کا مطلب ہے کہ یہ عمل سستا ہونا چاہیے اور ڈی این اے کی ترکیب سے وابستہ زہریلے ضمنی مصنوعات سے بچاتا ہے۔
تاہم، یہاں ادا کی گئی قیمت ڈیٹا کی زیادہ مقدار کی وجہ سے ہے جسے ڈی این اے کے دیئے گئے اسٹرینڈ پر محفوظ کیا جا سکتا ہے۔ ’ہم نے کثافت میں تقریباً 50 گنا نقصان کا تخمینہ لگایا (ڈی این اے کی ترکیب کی تکنیک کے مقابلے میں)۔‘

ڈی این اے میں ڈیٹا کو ذخیرہ کرنے کا ایک اور تجرباتی طریقہ، جس کے بارے میں اطلاع ہارورڈ کے سائنسدانوں نے 2017 میں دی تھی، ایک زندہ خلیے میں پہلے سے موجود ’ڈی این اے اسٹرینڈ‘ میں نیوکلیوٹائڈز کے ٹکڑوں کو خوراک دینا شامل ہے، جس میں ڈی این اے کے ٹکڑوں کو مدافعتی دفاعی طریقہ کار کے طور پر شامل کیا جاتا ہے۔ ٹیم نے ’ایڈوئیرڈ میوبرج‘ کی 1878 کے ایک فلم کا ایک سرپٹ گھوڑے کا کلپ ایک بیکٹیریم میں داخل کیا۔
میلینکووچ کہتے ہیں کہ اس کا ’ٹریس ایک زندہ حیاتیات میں چھوڑ دیا جاتا ہے۔‘ جب تک وہ جاندار موجود ہے، بشمول اس کی اولاد، معلومات کو ذخیرہ کیا جاتا ہے، حالانکہ یہ وقت کے ساتھ تبدیل ہو کر معلومات کو تبدیل کر سکتا ہے۔
لنکوو کا کہنا ہے کہ چونکہ ہم فوسلز سے ڈیٹا نکال سکتے ہیں، ہمیں پورا یقین ہے کہ ڈی این اے کا ذخیرہ طویل عرصے تک چل سکتا ہے۔ ’لہذا ایک دلچسپ سوال دراصل یہ نہیں ہے کہ میڈیا، ڈی این اے کے مالیکیولز کب تک قائم رہیں گے، لیکن کیا ہم 1000 سالوں میں ڈیٹا کو پڑھنے کے قابل ہو جائیں گے؟‘
لنکوو کی تنظیمڈی این اے ڈیٹا سٹوریج الائنس نامی ایک گروپ کا حصہ ہے جو اس بات پر غور کر رہا ہے کہ ہم کس طرح اس بات کو یقینی بنا سکتے ہیں کہ ہم مستقبل کی صدیوں میں ڈیٹا کو ڈی کوڈ کر سکیں گے۔ اس کے ورکنگ گروپس میں سے ایک، روزیٹا اسٹون گروپ، اس بات پر غور کر رہا ہے کہ اپنے ڈی این اے سٹوریج آرکائیو کو کیسے پڑھا جائے اس کے لیے ایک عالمگیر گائیڈ کیسے بنایا جائے۔
آج ڈی این اے پڑھنے کے ساتھ کئی چیلنجز درپیش ہیں۔ سب سے پہلے، آپ کو اسے ترتیب دینے کی ضرورت ہے۔ اس میں عام مالیکیولر تکنیک پی سی آر کا استعمال شامل ہے تاکہ ڈی این اے کے اس حصے کی کھربوں کاپیاں بنائی جائیں جسے آپ ڈی کوڈ کرنا چاہتے ہیں۔ بدقسمتی سے، اس وجہ سے کئی غلطیاں ہو سکتی ہیں۔ زیلنسکی کا کہنا ہے کہ ’ان میں سے بہت سی غلطیوں کو ڈی کوڈنگ میں آسانی سے سنبھالا جا سکتا ہے، جب آپ اس ڈی این اے کو اپنے ڈیٹا میں ڈی کوڈ کرتے ہیں۔‘
اگلی سیکوینسنگ خود آتی ہے، اور یہاں بھی ایک رکاوٹ ہے۔ فی الحال سیکوینسنگ ٹیبل ٹاپ مشینوں میں کی جاتی ہے جس کو چلانے میں عام طور پر کئی گھنٹے لگتے ہیں۔ لہذا ڈیٹا اسٹوریج کی یہ شکل بالکل فوری رسائی کا نظام نہیں ہے۔
ایک چیز جو انتظار کے ان اوقات کو بہتر بنائے گی وہ ہے ’بے ترتیب رسائی‘، آپ جس چیز کی تلاش کر رہے ہیں اسے بازیافت کرنے کے لیے ڈیٹا کو اندر اور باہر کرنے کی صلاحیت، لہذا آپ کو پوری طرح سے سیکونسنگ کرنے کی ضرورت نہیں ہے۔ ڈی این اے سٹوریج سسٹم کے ساتھ ڈی این اے اسٹرینڈز کے آخر میں ‘بار کوڈ’ کا اضافہ کرکے اس کا مظاہرہ کیا گیا ہے۔
لنکوو کہتے ہیں کہ تاہم موجودہ ڈی این اے مالیکیولز کافی مختصر ہیں، 150 یا 200 بیس جوڑے، لہذا اس جگہ کے کچھ حصے کو بار کوڈ کے ذریعے ڈی این اے اسٹرینڈ کی شناخت کرنے کے لیے استعمال کرنے سے اس ڈیٹا کو لکھنے کے لیے اور بھی کم جگہ رہ جاتی ہے جسے آپ اسٹور کرنا چاہتے ہیں۔
’یہ کافی سنگین مسئلہ ہے۔ لیکن ایک بار جب ٹیکنالوجی بہت بہتر ہو جاتی ہے اور ہم ہزاروں یا دسیوں ہزار نیوکلیوٹائڈز [بیس پیئرز] کے ساتھ بہت طویل مالیکیول لکھ سکتے ہیں، تو یہ مسئلہ ختم ہونا شروع ہو جائے گا۔

بے ترتیب رسائی کو بہتر بنانے کے لیے ایک اور طریقہ میں، باتھ کی ٹیم نے مالا کی سطح پر نیوکلیوٹائڈز کے چھوٹے اسٹرینڈز کا استعمال کرتے ہوئے لیبل والے سلیکا موتیوں میں ڈی این اے کی پٹیوں کو لپیٹ دیا۔ باتھ کہتے ہیں کہ ’جس طرح آپ کسی سپر مارکیٹ میں مصنوعات کو منفرد طریقے سے شناخت کرنے کے لیے بار کوڈ لگاتے ہیں، اسی طرح ہم ڈی این اے کے ان چھوٹے کیپسول کو نیوکلک ایسڈ کا استعمال کرتے ہوئے بارکوڈ لگاتے ہیں۔‘
یہ ابھی تک واضح نہیں ہے کہ ہم ڈی این اے میں محفوظ معلومات کو ورکنگ کمپیوٹرز میں کیسے ضم کر سکتے ہیں۔باتھ کی ٹیم نے ڈی این اے کے لیے فائل سسٹم بنانے کا تجربہ کیا ہے۔
باتھ کہتے ہیں کہ ’اس قسم کی ڈی این اے معلومات کی مائع یا ٹھوس حالت کو کسی ایسی چیز میں تبدیل کرتی ہے جو کمپیوٹر کی ہارڈ ڈرائیو سے زیادہ مشابہت رکھتی ہے جہاں آپ کے پاس گوگل جیسے سرچ انجن جیسی کسی چیز کے ذریعے تلاش کرنے کی صلاحیت بھی ہوتی ہے۔‘
یہاں تک کہ مائیکروسافٹ اس بات کی کھوج کر رہا ہے کہ وہ کمپیوٹر ڈیزائن میں بائیو مالیکیولز کو کیسے شامل کر سکتا ہے۔
تاہم، وسیع پیمانے پر ڈی این اے کی ترکیب خطرات کے ساتھ آئے گی۔ لوگ ڈیٹا کے علاوہ دیگر چیزوں کو ذخیرہ کرنے کے لیے اسے استعمال کرنے کی کوشش کر سکتے ہیں۔ نظری طور پر، لوگ وائرس یا بیکٹیریا کی ترکیب کر سکتے ہیں، زیلنسکی کہتے ہیں، یا کسی کا ڈی این اے بھی بنا سکتے ہیں اور اسے جرم کے مقام پر چھوڑ سکتے ہیں
وہ کہتی ہیں کہ ’دراصل ان میں سے بہت سی پائپ لائنوں میں ایسے چیک موجود ہیں جو ڈیٹا تیار کرتے ہیں کہ وہ اسے معلوم جینومز کے خلاف چیک کریں گے تاکہ یہ یقینی بنایا جا سکے کہ وہاں کچھ بھی حقیقی نہیں ہے، کچھ بھی نقصان دہ نہیں، جیسا کہ پیتھوجینز کی سیکوینسنگ۔‘
باتھ اس بات سے اتفاق کرتا ہے کہ رازداری کے ’بہت زیادہ‘ مسائل اور خطرات ہیں۔ وہ نوٹ کرتا ہے کہ بہت سی کمپنیاں کرہ ارض پر موجود ہر شخص کے ڈی این اے کی فہرست بنانے کی کوشش کر رہی ہیں۔ دوسروں نے نشاندہی کی ہے کہ یہ تصور کرنا کتنا خوفناک ہے کہ کوئی شخص ایک چھوٹے سے ڈیٹا سٹوریج سسٹم میں اربوں انسانوں کے ڈی این اے کی ترتیب کا ذخیرہ رکھ سکتا ہے۔
باتھ کہتے ہیں کہ ’ہمیں اس کے ارد گرد ٹیکنالوجیز بنانے کی ضرورت ہے، کیونکہ اگر ہم ایسا نہیں کرتے ہیں، تو ہم ان خطرات کو کم کرنے یا انہیں سمجھنے کے قابل نہیں ہوں گے، یہ ایک بہت ہی نامعلوم اور بے قابو ادارہ ہو گا۔‘
اس پر غور کرتے ہوئے، ڈی این اے ڈیٹا سٹوریج کے متبادل کے بارے میں سوچنا ضروری ہے۔ ساؤتھمپٹن یونیورسٹی میں آپٹیکل الیکٹرانکس کے پروفیسر پیٹر کازانسکی نے ایک آپٹیکل سٹوریج ٹیکنالوجی بنائی ہے جس کے بارے میں ان کے خیال میں ایک قابل دعویدار ہے۔ وہ کہتے ہیں کہ یہ لاکھوں یا اربوں سال تک چل سکتی ہے۔
ٹیم فیمٹوسیکنڈ (ایک سیکنڈ کے ایک اربویں کا ایک ملینواں حصہ) لیزر رائٹنگ کے ساتھ کام کرتی ہے – آنکھوں کی سرجری میں استعمال ہونے والی قسم کے لیزر کا استعمال کرتے ہوئے پائیدار سلیکا گلاس ڈسکوں پر معلومات کو کھینچنا۔ تیز، مختصر لیزر دالیں ایک خاص طریقے سے ایک مائیکرو دھماکہ بنانے کے لیے مرکوز ہوتی ہیں جس سے شیشے میں ایک چھوٹا سا سوراخ ہوتا ہے۔
کازانسکی کہتے ہیں کہ ’ہم نے دریافت کیا کہ ان حالات میں بہت چھوٹے نینو ڈھانچے بن سکتے ہیں۔ اور ہم ان ڈھانچے کو معلومات کو انکوڈ کرنے کے لیے استعمال کرتے ہیں۔‘
کازانسکی کہتے ہیں کہ یہ عمل سی ڈی اور ڈی وی ڈی کو لیزر لائٹ پولیمر یا ڈائی کا استعمال کرتے ہوئے جلانے کے طریقے سے ملتا جلتا ہے، لیکن یہاں ڈھانچے چھوٹے اور ناقابل یقین حد تک مستحکم ہیں، کم از کم 1,000 سیلسیس تک کے درجہ حرارت میں زندہ رہتے ہیں اور تابکاری سے متاثر نہیں ہوتے۔ وہ کہتے ہیں کہ ’(ہمارے) سٹوریج کا ایک فائدہ، سب سے اہم، پائیداری ہے۔ یہ تقریباً ہمیشہ کے لیے قائم رہ سکتا ہے۔‘
یہ ٹیکنالوجی پانچ جہتوں میں معلومات تیار کرتی ہے: ایک سوراخ کے ذریعہ بنائے جانے والے معمول کے تین جہتوں کے اوپر، سوراخ کی سمت اور شکل کو بھی کنٹرول کیا جا سکتا ہے، جس سے ڈیٹا کو زیادہ ذخیرہ کیا جا سکتا ہے۔ یہ کثافت کبھی بھی ڈی این اے کے قریب نہیں آ سکتی ہیں، لیکن اینچنگ میں تہوں کی تعداد میں اضافے سے یہ آہستہ آہستہ بڑھ رہی ہے۔

اب تک، انسانی حقوق کا عالمی اعلامیہ، میگنا کارٹا، کنگ جیمز بائبل اور دی ہچ ہائیکرز گائیڈ ٹو دی گلیکسی سمیت دستاویزات سبھی کو ٹیکنالوجی کا استعمال کرتے ہوئے ذخیرہ کیا گیا ہے۔ 2018 میں ایلون مسک نے آئیزک آسیموو کی سائنس فکشن سیریز فاؤنڈیشن کی ایک کندہ کاری والی شکل ’فیلکن ہیوی‘ راکٹ پر خلا میں بھیجی، جبکہ مائیکرو سافٹ نے 1978 کی پوری سپرمین فلم کو شیشے میں محفوظ کر رکھا ہے۔
یہاں تک کہ آرٹسٹ میکا تاجیما نے اس طریقہ کو استعمال کرتے ہوئے ’انسانی جذبات‘ کا ڈیٹا بھی ذخیرہ کیا ہے، اس نے 2020 میں جاپان میں پوسٹ کی گئی تمام ٹویٹس کو اکٹھا اور سٹور کیا۔
کازانسکی کا کہنا ہے کہ ’ہم ایک ایسا عمل استعمال کرتے ہیں جیسا کہ قدیم لوگ استعمال کرتے تھے۔ انہوں نے اوزاروں سے پتھر پر نشانات بنائے تھے۔ یہ مواد کی میکانکی یا جسمانی تبدیلی ہے۔ اس لیے اس قسم کی جسمانی تبدیلی یا مواد میں سوراخ کرنا معلومات کو محفوظ کرنے کا ایک بہت قدیم طریقہ ہے۔‘
ڈی این اے سٹوریج کی طرح اس طرح سے ڈیٹا کو ذخیرہ کرنے کے لیے ایک اہم انتباہ لکھنے کی رفتار ہے۔ کازانسکی کا کہنا ہے کہ ان کی ٹیم اب 500کلو بائیٹس فی سیکنڈ کی رفتار سے لکھ سکتی ہے، جو ایک دہائی قبل ابتدائی تجربے میں زیادہ سے زیادہ 0.1 کلو بائیٹس فی سیکنڈ تھی۔
وہ کہتے ہیں کہ ’اسے عملی بنانے کے لیے، آپ کو کم از کم ایک ملین بائٹس (1,000kB) فی سیکنڈ لکھنے کی رفتار درکار ہے۔‘ ڈیٹا کو ایک اور رکاوٹ کا سامنا ہے، جسے فی الحال آپٹیکل مائکروسکوپ کا استعمال کرتے ہوئے دستی طور پر کرنے کی ضرورت ہے۔
’اسے عملی بنانے کے لیے، آپ کو ایک مشین بنانے کی ضرورت ہے جو صرف نمونہ لے، توجہ مرکوز کرے، حرکت کرے اور پڑھے۔‘
زیلنسکی کا کہنا ہے کہ ’میرے خیال میں کندہ کاری کسی بھی ماحولیاتی حالات کے لیے زیادہ حساس نہیں ہے۔ لہٰذا یہ اتنا گھنا نہیں ہے (جیسے ڈی این اے)، لیکن یہ اب بھی اہم ڈیٹا کو ذخیرہ کرنے کا ایک بہت ہی زیادہ موثر طریقہ ہے، اور آپ یقینی طور پر اس کے بارے میں بہت کم فکر کر سکتے ہیں۔ ہر سٹوریج ڈیوائس کے اپنے مواقع اور فوائد اور نقصانات ہوتے ہیں۔ اور میرے خیال میں ڈی این اے تکمیلی ہو سکتا ہے۔‘
دوسرے محققین ڈیٹا کو انکوڈنگ کرنے کے لیے مالیکیولر آپشنز کی پیروی کر رہے ہیں جن میں ڈی این اے شامل نہیں ہے، جیسے کہ وہ دوسرے قسم کے مصنوعی مالیکیولز کی زنجیروں کا استعمال کرتے ہیں جن کی ترکیب کرنا آسان اور سستا ہے۔ مثال کے طور پر ایک کوڈ کو صرف انفرادی مالیکیولز کے بڑے پیمانے پر کنٹرول کر کے بنایا جا سکتا ہے، جس میں مختلف صفروں اور ایک ہندسوں کی کمیتوں کے مختلف امتزاج کی نمائندگی کرتے ہیں۔
ہمارے پاس پہلے سے ہی ڈیجیٹل ڈیٹا کو ڈی این اے میں انکوڈ کرنے، اسے سمیٹنے اور اسے سینکڑوں یا ممکنہ طور پر ہزاروں سالوں تک محفوظ رکھنے کی صلاحیت ہے۔ یہاں اصل انتباہ یہ ہے کہ یہ کس ڈیٹا کے ساتھ کیا جائے یا ڈی این اے کی سیکوینسنگ کی رکاوٹ کو کیسے دور کیا جائے تاکہ ہمارے پاس اب تک کے اعداد و شمار سے کہیں زیادہ مقدار میں ذخیرہ کیا جا سکے۔
ایونکوف کہتے ہیں کہ ’میں ڈیٹا کو ذخیرہ کرنے کے لیے استعمال ہونے والے ڈی این اے کے بارے میں بہت پرجوش ہوں، (لیکن) مجھے لگتا ہے کہ ہمیں مزید 20 سال درکار ہیں، حالانکہ وہ نوٹ کرتے ہیں کہ کچھ کمپنیاں یقین رکھتی ہیں کہ ان کے پاس پانچ سالوں میں ایک قابل عمل پروڈکٹ تیار ہوجائے گی۔
زیلنسکی کا خیال ہے کہ انسان اگلے پانچ سے 10 سالوں میں کولڈ ڈیٹا کو ذخیرہ کرنے کے لیے ڈی این اے کا استعمال شروع کر دے گا جس تک ہمیں اکثر رسائی حاصل کرنے کی ضرورت نہیں ہو گی، جیسے اہم مالیاتی ریکارڈ یا تاریخی ڈیٹا۔ میں اس سے پوچھتا ہوں کہ کیا ایک دن ہم گھر کے آلات پر اپنا ڈی این اے پرنٹ کر سکتے ہیں۔ بالکل، مجھے لگتا ہے کہ یہ کسی بھی وقت ہوجائے گا۔’


















